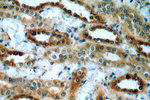
MT3 Antibody in Immunohistochemistry (Paraffin) (IHC (P))

Search
Proteintech
MT3 Polyclonal Antibody
{{$productOrderCtrl.translations['antibody.pdp.commerceCard.promotion.promotions']}}
{{$productOrderCtrl.translations['antibody.pdp.commerceCard.promotion.viewpromo']}}
{{$productOrderCtrl.translations['antibody.pdp.commerceCard.promotion.promocode']}}: {{promo.promoCode}} {{promo.promoTitle}} {{promo.promoDescription}}. {{$productOrderCtrl.translations['antibody.pdp.commerceCard.promotion.learnmore']}}
产品信息
12179-1-AP
种属反应
宿主/亚型
分类
类型
抗原
偶联物
形式
浓度
规格
纯化类型
保存液
内含物
保存条件
运输条件
产品详细信息
Immunogen sequence: MDPETCPCP SGGSCTCADS CKCEGCKCTS CKKSCCSCCP AECEKCAKDC VCKGGEAAEA EAEKCSCCQ (1-68 aa encoded by BC013081)
靶标信息
Metallothionein (MT) is a sulfhydryl- and cysteine-rich protein found in micro-organisms, plants and all invertebrate and vertebrate animals. Metallothioneins are a group of ubiquitous low-molecular-weight proteins that have functional roles in cell growth, repair and differentiation. Metallothionein are implicated primarily in metal ion detoxification as they are essential for the protection of cells against the toxicity of cadmium, mercury and copper. Metallothioneins are known to be broadly expressed in heart, liver, kidney, breast and testis tissue. Metallothionein 3, also known as MT-3 or GIFB (growth inhibitory factor), is a 68 amino acid protein that belongs to the type 1 family and Metallothionein superfamily. While highly expressed in astrocytes of the normal human brain, Metallothionein 3 expression is reduced in the brains of patients with Alzheimer disease.
仅用于科研。不用于诊断过程。未经明确授权不得转售。
篇参考文献 (0)
生物信息学
蛋白别名: GIF; GIFB; Growth inhibitory factor; metallothionein 3 (growth inhibitory factor (neurotrophic)); metallothionein III; Metallothionein-3; Metallothionein-III; MT-3; MT-III
基因别名: GIF; GIFB; GRIF; Mt-3; MT3; ZnMT3
UniProt ID: (Human) P25713, (Rat) P37361, (Mouse) P28184
Entrez Gene ID: (Human) 4504, (Rat) 117038, (Mouse) 17751